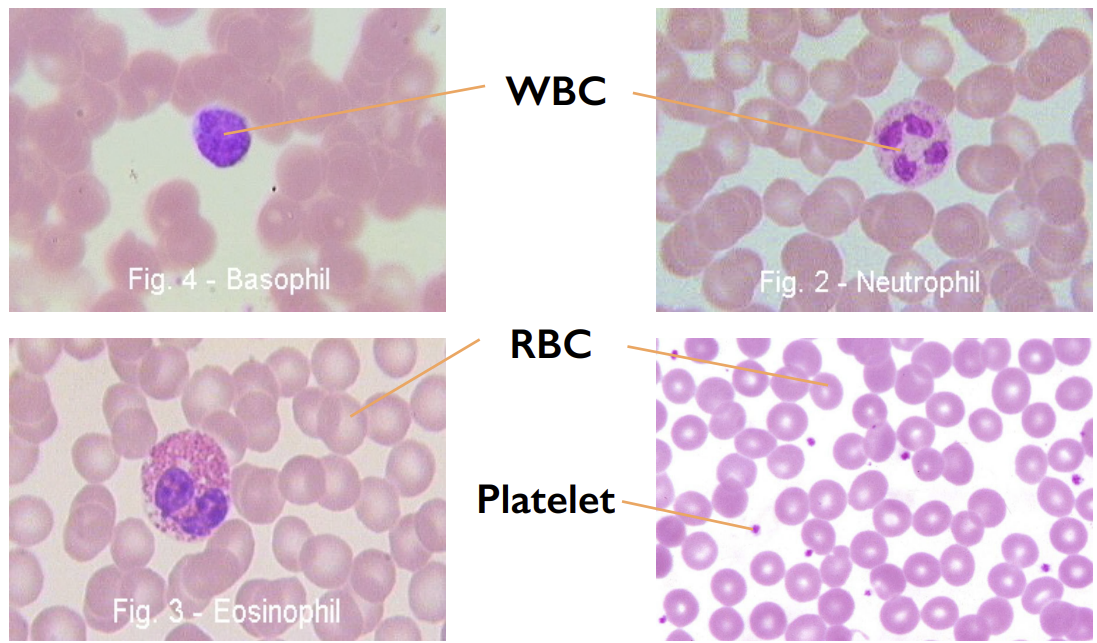

1/15
Vocabulary flashcards based on lecture notes about tissues and animal dissections.
Name | Mastery | Learn | Test | Matching | Spaced | Call with Kai |
|---|
No analytics yet
Send a link to your students to track their progress
Simple Squamous
Tissue found in lungs, endothelium of capillaries, blood vessels. Functions include gas exchange and diffusion.

Simple Cuboidal
Tissue found in kidney tubules and glands. Functions include secretion and absorption.

Simple Columnar
Tissue located in the GI tract and uterine tubes. Functions include secretion and absorption.

Pseudostratified Columnar
Tissue found in the trachea and nasal cavity; functions include movement of fluids (mucus) and protection.

Adipose Tissue
Tissue located under the skin and around the kidneys; functions include energy storage and insulation.

Blood
A fluid connective tissue containing red blood cells, white blood cells, and platelets.
Hyaline Cartilage
Cartilage found in embryonic skeletons and joint cavities providing support and cushioning.

Skeletal Muscle
Muscle tissue attached to the skeleton for voluntary movement.

Cardiac Muscle
Muscle tissue found in the heart for heart muscle contraction.

Smooth Muscle
Muscle tissue found in blood vessels and the GI tract for involuntary movement.

Nervous Tissue
Tissue found in the central and peripheral nervous systems for conducting nerve impulses.

Hydra
A cylindrical tube-shaped organism with tentacles used for capturing food.

Squid
External anatomy includes fins, arms, tentacles, mantle, eyes, collar, and funnel.

Earthworm
External anatomy includes mouth, prostomium, segment, and setae.

Crayfish
External anatomy includes cephalothorax, abdomen, telson, and uropod.

Frog
Viscera includes heart, liver, stomach, small intestine, and large intestine.
